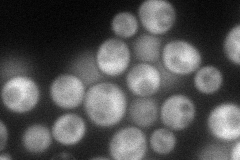
YPL101W
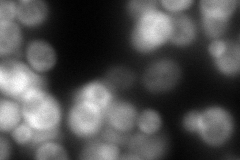
YPL101W
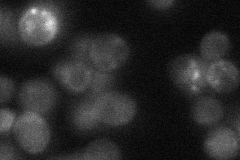
YPL101W

View description
Subunit of Elongator complex, which is required for modification of wobble nucleosides in tRNA; required for Elongator structural integrity
Localization:
Intensity:
Fold change:
Significance:
-
C’ GFP library in SD

below threshold14.47 -
N' NOP1pr-GFP in SD
cytosol86.1198 -
N' TEF2pr-mCherry in SD
cytosol98.3335 -
N' NATIVEpr-GFP in SD
below threshold22.284 -
N' TEF2pr-VC and Cyto-VN in SD

cytosol35.2728 -
C’ GFP library in SD+DTT

cytosol15.031.03No -
C’ GFP library in SD+H2O2

cytosol17.111.18No -
C’ GFP library in Starvation Media

cytosol16.81.16No -
C’ GFP library on the background of Pup2-DaMP

below threshold -
C’ GFP library on the background of CCT mutant

below threshold17.45221.20566No
